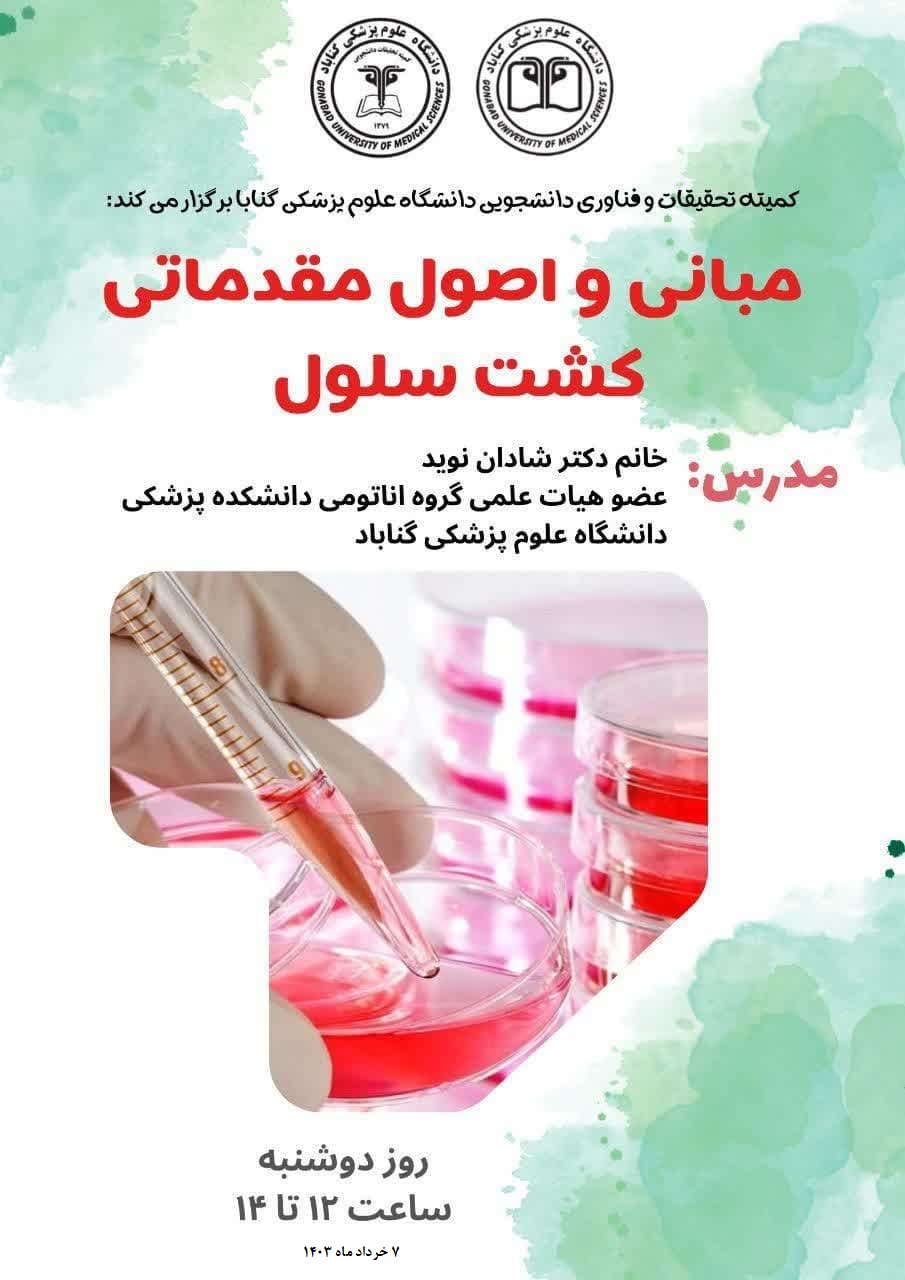

🔸 کمیته تحقیقات و فناوری دانشجویی دانشگاه علوم پزشکی گناباد برگزار میکند:
✅کارگاه مبانی و اصول مقدماتی کشت سلول
👤مدرس : خانم دکتر شادان نوید
عضو هیئت علمی گروه آناتومی دانشکده پزشکی دانشگاه علوم پزشکی گناباد
📆زمان برگزاری:
دوشنبه ۷ خردادماه ۱۴۰۳
ساعت ۱۲ الی ۱۴
🏢محل برگزاری: کلاس ۵ دانشکده پیراپزشکی(به صورت حضوری)
🔸ظرفیت: ۲۰ نفر
🔸ویژه تمامی دانشجویان علوم پزشکی گناباد
📄 همراه با ارائه گواهی معتبر
🔸جهت ثبت نام لطفا نام و نام خانوادگی، رشته و شماره دانشجویی خود را به آیدی تلگرام زیر ارسال کنید: 👇
@Fahim_sh79